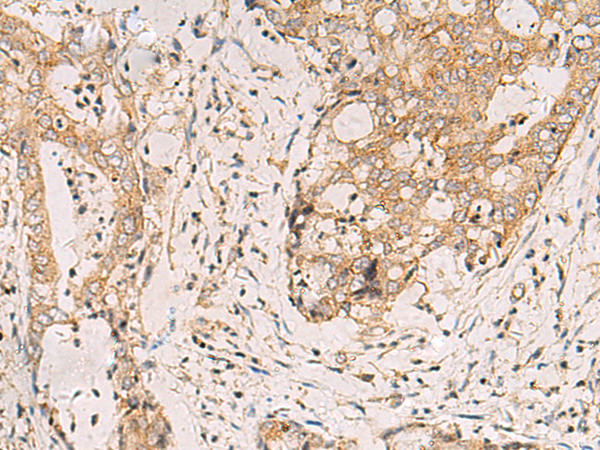
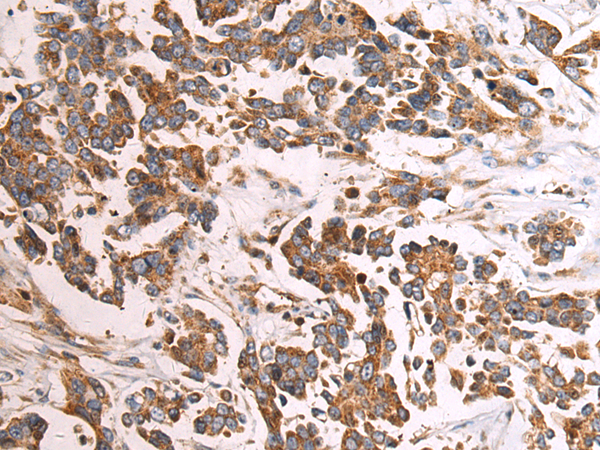

-
分类: 科研抗体货号: P10336别名: CATC2; RUFY3; ZFYVE7; CTRCT18应用: IHC反应种属: Human
-
分类: 科研抗体货号: P10320别名: PAFAHG应用: WB,IHC反应种属: Human, Mouse, Rat
-
分类: 科研抗体货号: P10335别名:应用: WB,IHC反应种属: Human, Mouse, Rat
-
分类: 科研抗体货号: P10347别名: SSB2; GRCC9应用: IHC反应种属: Human, Mouse, Rat
-
分类: 科研抗体货号: P10334别名: Ki; PA28G; HEL-S-283; PA28gamma; REG-GAMMA; PA28-gamma应用: IHC反应种属: Human, Mouse
-
分类: 科研抗体货号: P10343别名: bA321C24.3应用: IHC反应种属: Human, Mouse
-
分类: 科研抗体货号: P10333别名: RABIN3; RABIN8应用: IHC反应种属: Human, Mouse, Rat
-
分类: 科研抗体货号: P10342别名: CHBP2应用: WB,IHC反应种属: Human, Mouse
-
分类: 科研抗体货号: P10362别名: DRG1; LIP5; SBP1; DRG-1; My012; C6orf55; HSPC228应用: IHC反应种属: Human, Mouse
-
分类: 科研抗体货号: P10341别名: HEP27; SDR25C1应用: WB,IHC反应种属: Human

鄂公网安备42018502007531号
鄂公网安备42018502007531号

